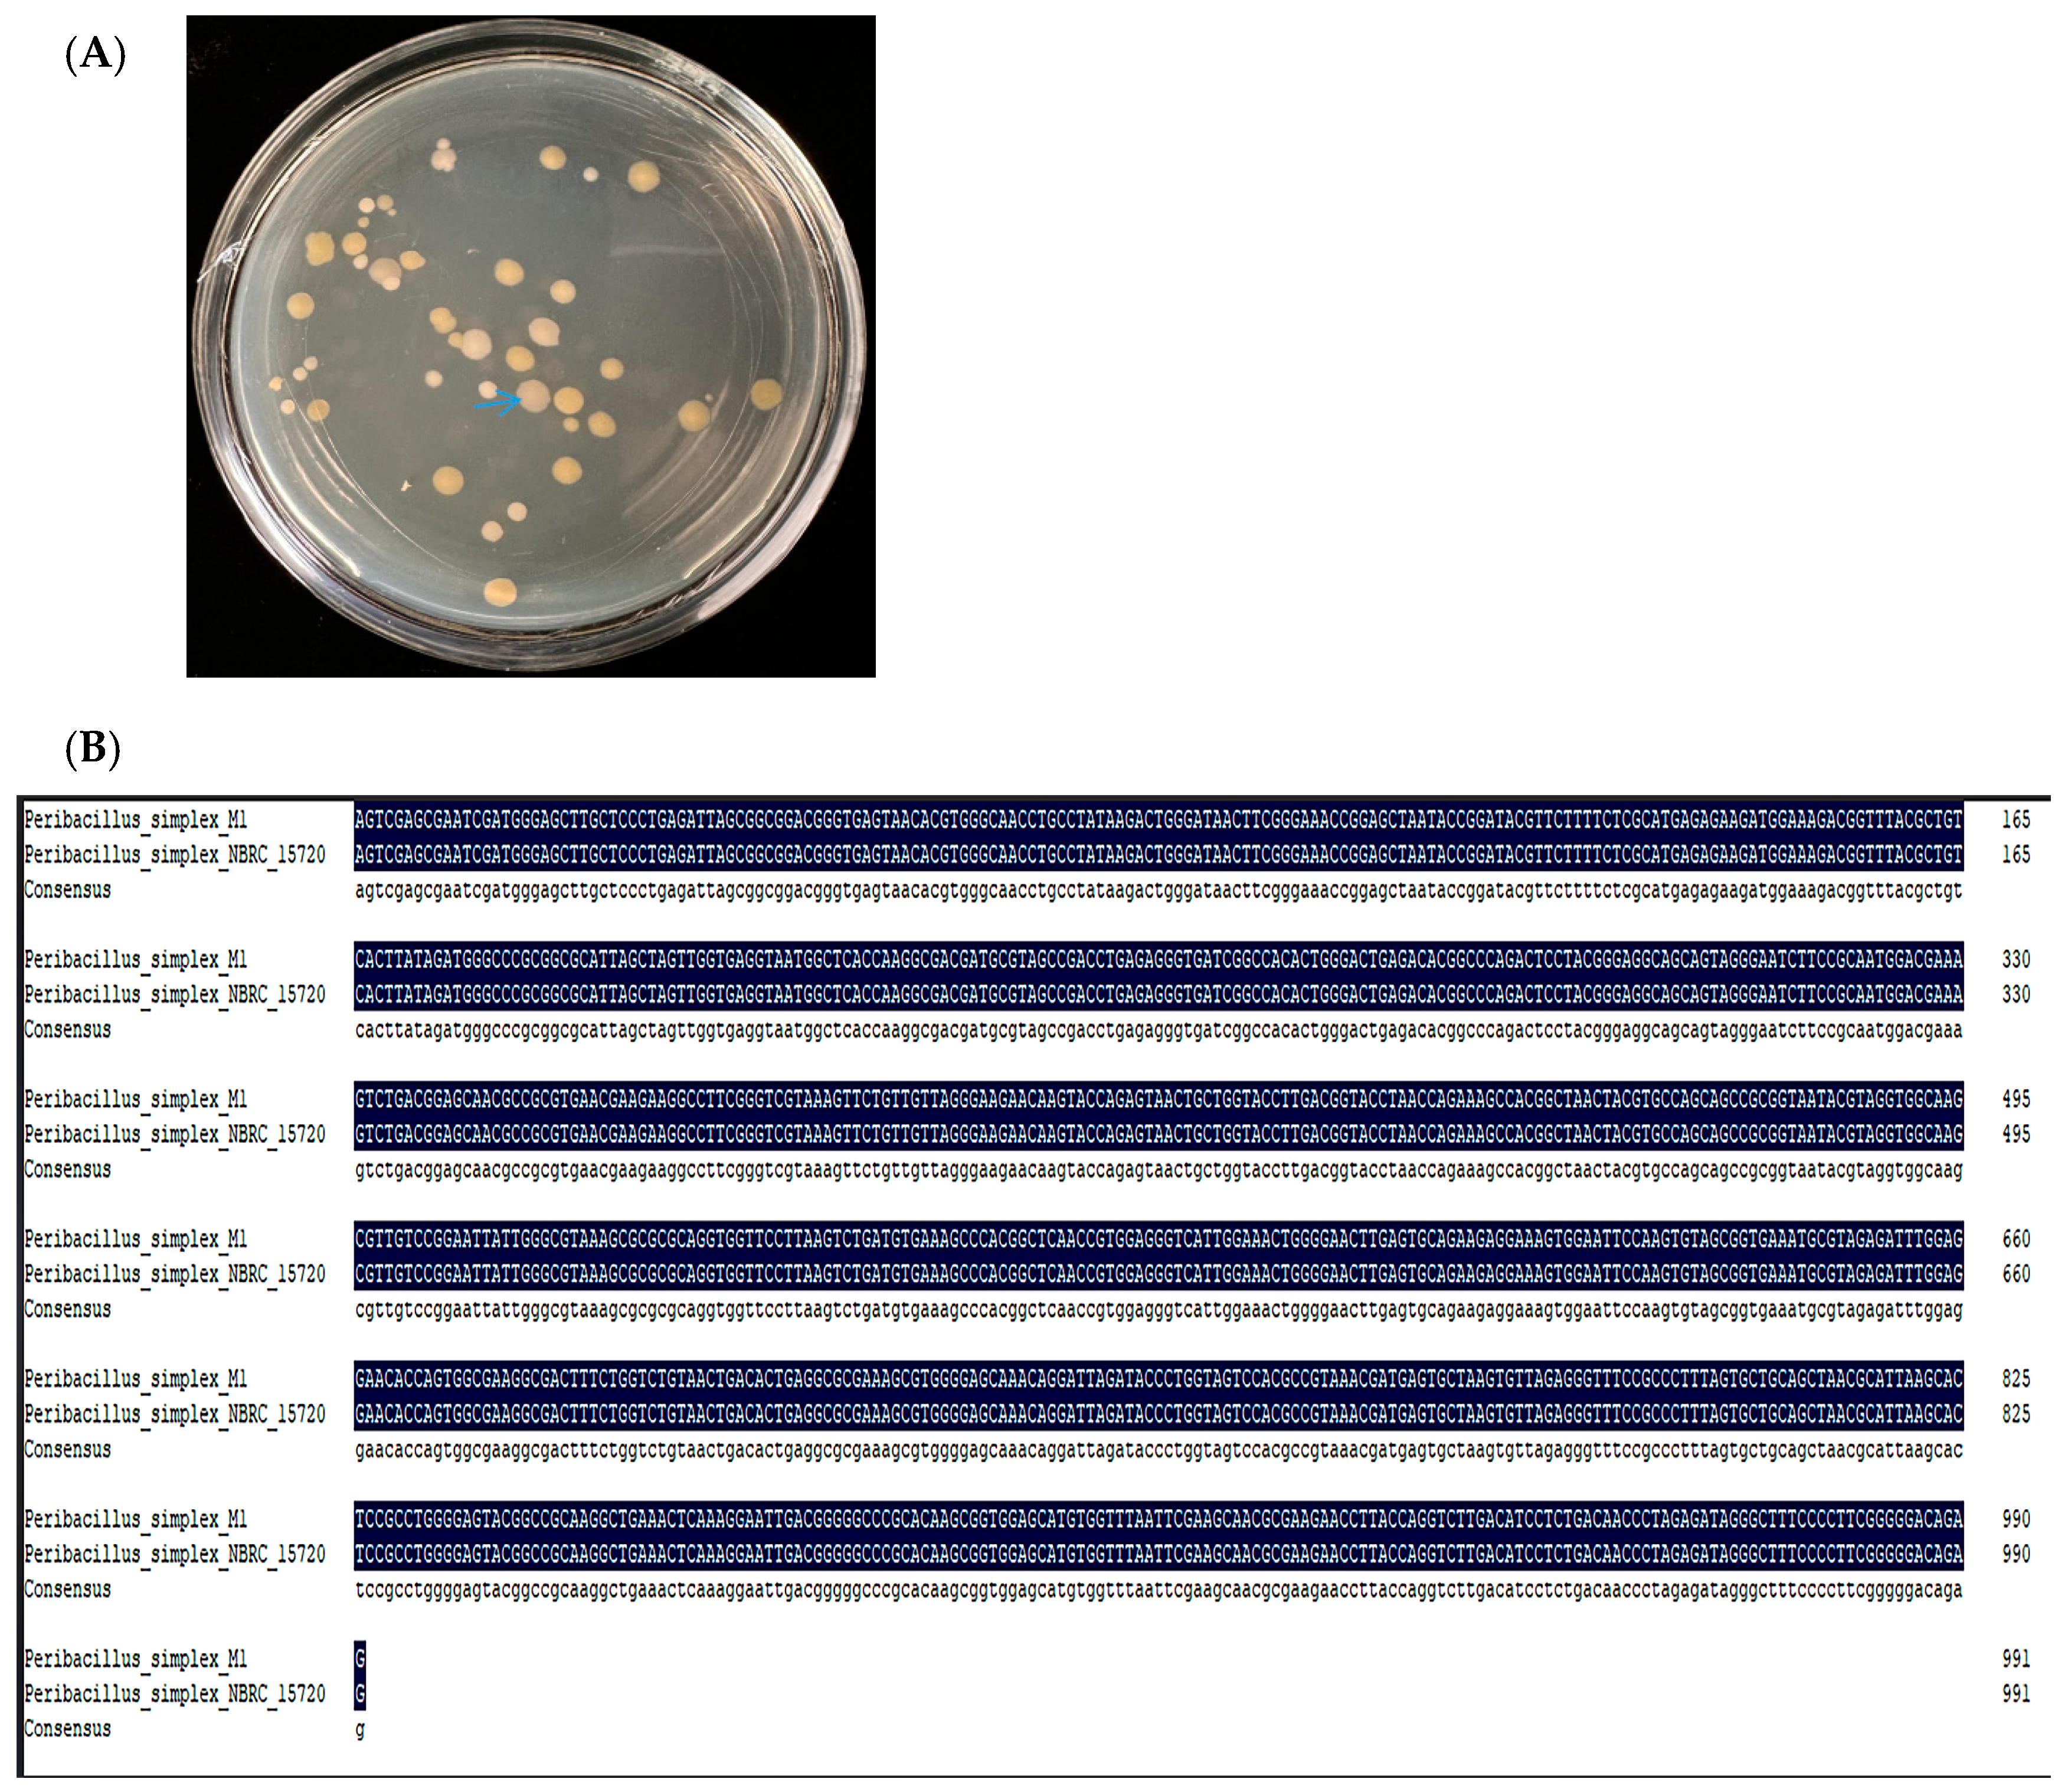
Ijms 25 10870 g001

Maize Endophytic Plant Growth-Promoting Bacteria Peribacillus simplex Can Alleviate Plant Saline and Alkaline Stress
Abstract
:1. Introduction
2. Results
2.1. Sequencing of the 16s rRNA Gene
2.2. The Bacterium Genome Sequence Analysis
2.3. The Bacterium Trait
2.4. Growth of P. simplex M1 under NaHCO3 Stress and Different pH
2.4.1. Growth of P. simplex M1 under Different Concentrations of NaHCO3
2.4.2. Growth of P. simplex M1 under Different pH Value
2.5. Effect of P. simplex M1 Bacterial Isolates on Growth of Maize
2.5.1. Germination of Maize Seeds under Normal Growth or NaHCO3 Stresses Conditions
2.5.2. TTC, DAB, and NBT Staining
2.6. The Effect of P. simplex M1 on the Maize Seedlings
2.6.1. P. simplex M1 Bacterial Strains to Colonize Seedling Roots
2.6.2. The Effect of P. simplex M1 on the Maize Seedling
2.6.3. Antioxidant Enzyme Determination of Maize Seedlings under 400 mM NaHCO3 Stress
3. Discussion
4. Materials and Methods
4.1. Isolation and Identification of Selected Bacterium
4.2. The Bacterium Genome Analysis
4.3. Evaluation of the Bacterium Traits
4.4. Abiotic Stress-Tolerance Estimation for P. simplex M1
4.5. Effects of P. simplex M1 on Maize Plants Using Inoculation Experiments
4.5.1. P. simplex M1 Affect Maize Seed Germination Assay
4.5.2. P. simplex M1 Affect Maize Seedlings Using Pot Experiment
4.6. Statistical Analysis
Author Contributions
Funding
Institutional Review Board Statement
Informed Consent Statement
Data Availability Statement
Conflicts of Interest
References
- Liu, L.; Wang, B. Protection of halophytes and their uses for cultivation of saline-alkali soil in China. Biology 2021, 10, 353. [Google Scholar] [CrossRef]
- Srivastava, S.; Bist, V.; Srivastava, S.; Singh, P.C.; Trivedi, P.K.; Asif, M.H.; Chauhan, P.S.; Nautiyal, C.S. Unraveling aspects of Bacillus amyloliquefaciens mediated enhanced production of rice under biotic stress of Rhizoctonia solani. Front. Plant Sci. 2016, 7, 587. [Google Scholar] [CrossRef]
- Ludwig, M.; Wilmes, P.; Schrader, S. Measuring soil sustainability via soil resilience. Sci. Total Environ. 2018, 626, 1484–1493. [Google Scholar] [CrossRef]
- Galvez Ranilla, L. The application of metabolomics for the study of cereal corn (Zea mays L.). Metabolites 2020, 10, 300. [Google Scholar] [CrossRef]
- Ma, Y.; Tashpolat, N. Current status and development trend of soil salinity monitoring research in China. Sustainability 2023, 15, 5874. [Google Scholar] [CrossRef]
- Revilla, P.; Alves, M.L.; Andelković, V.; Balconi, C.; Dinis, I.; Mendes-Moreira, P.; Redaelli, R.; Ruiz de Galarreta, J.I.; Vaz Patto, M.C.; Žilić, S. Traditional foods from maize (Zea mays L.) in Europe. Front. Nutr. 2022, 8, 683399. [Google Scholar] [CrossRef]
- Notununu, I.; Moleleki, L.; Roopnarain, A.; Adeleke, R. Effects of plant growth-promoting rhizobacteria on the molecular responses of maize under drought and heat stresses: A review. Pedosphere 2022, 32, 90–106. [Google Scholar] [CrossRef]
- Chávez-Arias, C.C.; Ligarreto-Moreno, G.A.; Ramírez-Godoy, A.; Restrepo-Díaz, H. Maize responses challenged by drought, elevated daytime temperature and arthropod herbivory stresses: A physiological, biochemical and molecular view. Front. Plant Sci. 2021, 12, 702841. [Google Scholar] [CrossRef]
- Mahdi, I.; Allaoui, A.; Fahsi, N.; Biskri, L. Bacillus velezensis QA2 potentially induced salt stress tolerance and enhanced phosphate uptake in quinoa plants. Microorganisms 2022, 10, 1836. [Google Scholar] [CrossRef]
- Etesami, H.; Maheshwari, D.K. Use of plant growth promoting rhizobacteria (PGPRs) with multiple plant growth promoting traits in stress agriculture: Action mechanisms and future prospects. Ecotoxicol. Environ. Saf. 2018, 156, 225–246. [Google Scholar] [CrossRef]
- Andrés-Barrao, C.; Lafi, F.F.; Alam, I.; de Zélicourt, A.; Eida, A.A.; Bokhari, A.; Alzubaidy, H.; Bajic, V.B.; Hirt, H.; Saad, M.M. Complete genome sequence analysis of Enterobacter sp. SA187, a plant multi-stress tolerance promoting endophytic bacterium. Front. Microbiol. 2017, 8, 2023. [Google Scholar] [CrossRef] [PubMed]
- Joshi, H.; Bisht, N.; Mishra, S.K.; Prasad, V.; Chauhan, P.S. Bacillus amyloliquefaciens modulate carbohydrate metabolism in rice-PGPR cross-talk under abiotic stress and phytohormone treatments. J. Plant Growth Regul. 2023, 42, 4466–4483. [Google Scholar] [CrossRef]
- Song, X.; Fu, C.-H.; Li, J.-H.; Sun, X.-T.; Wei, Y.-Z.; Xiao, H.-C.; Li, W.-Y.; Qin, L.-G. Research Progress on Molecular Mechanism of Endophytes Improving the Drought Resistance and Salt Tolerance of Plant. Chinede J. Grassl. 2024, 32, 13. [Google Scholar]
- Manetsberger, J.; Caballero Gómez, N.; Benomar, N.; Christie, G.; Abriouel, H. Characterization of the culturable sporobiota of Spanish olive groves and its tolerance toward environmental challenges. Microbiol. Spectr. 2023, 11, e04013–e04022. [Google Scholar] [CrossRef] [PubMed]
- Manetsberger, J.; Caballero Gómez, N.; Soria-Rodríguez, C.; Benomar, N.; Abriouel, H. Simply Versatile: The Use of Peribacillus simplex in Sustainable Agriculture. Microorganisms 2023, 11, 2540. [Google Scholar] [CrossRef]
- Fajardo-Cavazos, P.; Maughan, H.; Nicholson, W.L. Evolution in the Bacillaceae. Microbiol. Spectr. 2016, 2, 21–58. [Google Scholar] [CrossRef]
- Gottheil, O. Botanische beschreibung einiger bodenbakterien. Zentbl. Bakteriol. Parasitenkd. Infekt. Hyg. Abt. II 1901, 7, 680–691. [Google Scholar]
- Validation of the publication of new names and new combinations previously effectively published outside the IJSB. Int. J. Syst. Bacteriol. 1988, 38, 220–222. [CrossRef]
- Patel, S.; Gupta, R.S. A phylogenomic and comparative genomic framework for resolving the polyphyly of the genus Bacillus: Proposal for six new genera of Bacillus species, Peribacillus gen. nov., Cytobacillus gen. nov., Mesobacillus gen. nov., Neobacillus gen. nov., Metabacillus gen. nov. and Alkalihalobacillus gen. nov. Int. J. Syst. Evol. Microbiol. 2020, 70, 406–438. [Google Scholar]
- Martínez-Hidalgo, P.; Flores-Félix, J.D.; Sánchez-Juanes, F.; Rivas, R.; Mateos, P.F.; Santa Regina, I.; Peix, Á.; Martínez-Molina, E.; Igual, J.M.; Velázquez, E. Identification of canola roots endophytic bacteria and analysis of their potential as biofertilizers for canola crops with special emphasis on sporulating bacteria. Agronomy 2021, 11, 1796. [Google Scholar] [CrossRef]
- Santoyo, G.; Moreno-Hagelsieb, G.; del Carmen Orozco-Mosqueda, M.; Glick, B.R. Plant growth-promoting bacterial endophytes. Microbiol. Res. 2016, 183, 92–99. [Google Scholar] [CrossRef] [PubMed]
- Yao, Z.; Chen, Y.; Luo, S.; Wang, J.; Zhang, J.; Zhang, J.; Tian, C.; Tian, L. Culturable screening of plant growth-promoting and biocontrol bacteria in the Rhizosphere and Phyllosphere of wild Rice. Microorganisms 2022, 10, 1468. [Google Scholar] [CrossRef] [PubMed]
- Hassen, A.I.; Labuschagne, N. Root colonization and growth enhancement in wheat and tomato by rhizobacteria isolated from the rhizoplane of grasses. World J. Microbiol. Biotechnol. 2010, 26, 1837–1846. [Google Scholar] [CrossRef]
- Erturk, Y.; Ercisli, S.; Haznedar, A.; Cakmakci, R. Effects of plant growth promoting rhizobacteria (PGPR) on rooting and root growth of kiwifruit (Actinidia deliciosa) stem cuttings. Biol. Res. 2010, 43, 91–98. [Google Scholar] [CrossRef]
- Schwartz, A.R.; Ortiz, I.; Maymon, M.; Herbold, C.W.; Fujishige, N.A.; Vijanderan, J.A.; Villella, W.; Hanamoto, K.; Diener, A.; Sanders, E.R. Bacillus simplex—A little known PGPB with anti-fungal activity—Alters pea legume root architecture and nodule morphology when coinoculated with Rhizobium leguminosarum bv. viciae. Agronomy 2013, 3, 595–620. [Google Scholar] [CrossRef]
- Al-Sman, K.M.; Abo-Elyousr, K.; Eraky, A.; El-Zawahry, A. Potential activities of Bacillus simplex as a biocontrol agent against root rot of Nigella sativa caused by Fusarium camptoceras. Egypt. J. Biol. Pest Control. 2019, 29, 1–6. [Google Scholar] [CrossRef]
- Chandra, P.; Khobra, R.; Sundha, P.; Sharma, R.K.; Jasrotia, P.; Chandra, A.; Singh, D.P.; Singh, G.P. Plant growth promoting Bacillus-based bio formulations improve wheat rhizosphere biological activity, nutrient uptake and growth of the plant. Acta Physiol. Plant. 2021, 43, 1–12. [Google Scholar] [CrossRef]
- Cochard, B.; Giroud, B.; Crovadore, J.; Chablais, R.; Arminjon, L.; Lefort, F. Endophytic PGPR from tomato roots: Isolation, in vitro characterization and in vivo evaluation of treated tomatoes (Solanum lycopersicum L.). Microorganisms 2022, 10, 765. [Google Scholar] [CrossRef]
- Mushtaq, Z.; Nazir, A.; Asghar, H.N.; Zahir, Z.A. Interactive effect of siderophore-producing bacteria and l-tryptophan on physiology, tuber characteristics, yield, and iron concentration of potato. Potato Res. 2022, 65, 1015–1027. [Google Scholar] [CrossRef]
- Akinrinlola, R.J.; Yuen, G.Y.; Drijber, R.A.; Adesemoye, A.O. Evaluation of Bacillus strains for plant growth promotion and predictability of efficacy by in vitro physiological traits. Int. J. Microbiol. 2018, 2018, 5686874. [Google Scholar] [CrossRef]
- Senger, M.; Moresco, E.; Dalbosco, M.; Santin, R.; Inderbitzin, P.; Barrocas, E.N. Methods to quantify Bacillus simplex-based inoculant and its effect as a seed treatment on field-grown corn and soybean in Brazil. J. Seed Sci. 2022, 44, e202244041. [Google Scholar] [CrossRef]
- Misra, S.; Chauhan, P.S. ACC deaminase-producing rhizosphere competent Bacillus spp. mitigate salt stress and promote Zea mays growth by modulating ethylene metabolism. 3 Biotech 2020, 10, 119. [Google Scholar] [CrossRef] [PubMed]
- Delcher, A.L.; Bratke, K.A.; Powers, E.C.; Salzberg, S.L. Identifying bacterial genes and endosymbiont DNA with Glimmer. Bioinformatics 2007, 23, 673–679. [Google Scholar] [CrossRef] [PubMed]
- Ahmad, P.; Azooz, M.M.; Prasad, M.N.V. Ecophysiology and Responses of Plants under Salt Stress; Springer Science & Business Media: New York, NY, USA, 2012. [Google Scholar]
- Mishra, J.; Prakash, J.; Arora, N.K. Role of beneficial soil microbes in sustainable agriculture and environmental management. Clim. Change Environ. Sustain. 2016, 4, 137–149. [Google Scholar] [CrossRef]
- Ojuederie, O.B.; Babalola, O.O. Microbial and plant-assisted bioremediation of heavy metal polluted environments: A review. Int. J. Environ. Res. Public Health 2017, 14, 1504. [Google Scholar] [CrossRef]
- Wang, Y.; Xu, C.; Wuriyanghan, H.; Lei, Z.; Tang, Y.; Zhang, H.; Zhao, X. Exogenous selenium endows salt-tolerant and salt-sensitive soybeans with salt tolerance through plant-microbial coactions. Agronomy 2023, 13, 2271. [Google Scholar] [CrossRef]
- Hayat, R.; Ali, S.; Amara, U.; Khalid, R.; Ahmed, I. Soil beneficial bacteria and their role in plant growth promotion: A review. Ann. Microbiol. 2010, 60, 579–598. [Google Scholar] [CrossRef]
- Yadav, A.N.; Kour, D.; Rana, K.L.; Kumar, V.; Dhaliwa, S.; Verma, P.; Singh, B.; Chauahan, V.S.; Sugitha, T.; Saxena, A.K. Plant microbiomes and its beneficial multifunctional plant growth promoting attributes. Int. J. Environ. Sci. Nat. Resour. 2017, 3, 1–8. [Google Scholar] [CrossRef]
- Ito, Y.; Yoshidome, D.; Hidaka, M.; Araki, Y.; Ito, K.; Kosono, S.; Nishiyama, M. Improvement of the nitrogenase activity in Escherichia coli that expresses the nitrogen fixation-related genes from Azotobacter vinelandii. Biochem. Biophys. Res. Commun. 2024, 728, 150345. [Google Scholar] [CrossRef]
- Tanigawa, R.; Shirokane, M.; Maeda, S.-I.; Omata, T.; Tanaka, K.; Takahashi, H. Transcriptional activation of NtcA-dependent promoters of Synechococcus sp. PCC 7942 by 2-oxoglutarate in vitro. Proc. Natl. Acad. Sci. USA 2002, 99, 4251–4255. [Google Scholar] [CrossRef]
- Rezakhani, L.; Motesharezadeh, B.; Tehrani, M.M.; Etesami, H.; Hosseini, H.M. Phosphate–solubilizing bacteria and silicon synergistically augment phosphorus (P) uptake by wheat (Triticum aestivum L.) plant fertilized with soluble or insoluble P source. Ecotoxicol. Environ. Saf. 2019, 173, 504–513. [Google Scholar] [CrossRef] [PubMed]
- Erturk, Y.; Ercisli, S.; Cakmakci, R. Yield and growth response of strawberry to plant growth-promoting rhizobacteria inoculation. J. Plant Res. 2012, 35, 817–826. [Google Scholar] [CrossRef]
- Wang, Y.; Sun, X.; Peng, J.; Li, F.; Ali, F.; Wang, Z. Regulation of seed germination: ROS, epigenetic, and hormonal aspects. J. Adv. Res. 2024, in press. [Google Scholar] [CrossRef] [PubMed]
- Alori, E.T.; Glick, B.R.; Babalola, O.O. Microbial phosphorus solubilization and its potential for use in sustainable agriculture. Front. Microbiol. 2017, 8, 971. [Google Scholar] [CrossRef] [PubMed]
- Olson, K.R.; Gao, Y.; DeLeon, E.R.; Arif, M.; Arif, F.; Arora, N.; Straub, K.D. Catalase as a sulfide-sulfur oxido-reductase: An ancient (and modern?) regulator of reactive sulfur species (RSS). Redox Biol. 2017, 12, 325–339. [Google Scholar] [CrossRef]
- AlAli, H.A.; Khalifa, A.; Almalki, M. Plant growth-promoting rhizobacteria from Ocimum basilicum improve growth of Phaseolus vulgaris and Abelmoschus esculentus. S. Afr. J. Bot. 2021, 139, 200–209. [Google Scholar] [CrossRef]
- Mehta, S.; Nautiyal, C. An efficient method for qualitative screening of phosphate-solubilizing bacteria. Curr. Microbiol. 2001, 43, 51–56. [Google Scholar] [CrossRef]
- Bric, J.M.; Bostock, R.M.; Silverstone, S.E. Rapid in situ assay for indoleacetic acid production by bacteria immobilized on a nitrocellulose membrane. Appl. Environ. Microbiol. 1991, 57, 535–538. [Google Scholar] [CrossRef]
- Yeole, R.D.; Dave, B.P.; Dube, H.C. Siderophore production by fluorescent pseudomonads colonizing roots of certain crop plants. Indian J. Exp. Biol. 2001, 39, 464–468. [Google Scholar]
- Guo, Z.; Zhao, J.; Wang, M.; Song, S.; Xia, Z. Sulfur dioxide promotes seed germination by modulating reactive oxygen species production in maize. Plant Sci. 2021, 312, 111027. [Google Scholar] [CrossRef]
- Kumar, D.; Yusuf, M.A.; Singh, P.; Sardar, M.; Sarin, N.B. Histochemical detection of superoxide and H2O2 accumulation in Brassica juncea seedlings. Bio-Protocol 2014, 4, e1108. [Google Scholar] [CrossRef]
- Wang, P.; Qi, S.; Wang, X.; Dou, L.; Jia, M.-a.; Mao, T.; Guo, Y.; Wang, X. The OPEN STOMATA1–SPIRAL1 module regulates microtubule stability during abscisic acid-induced stomatal closure in Arabidopsis. Plant Cell 2023, 35, 260–278. [Google Scholar] [CrossRef] [PubMed]
- Beyer, W.F., Jr.; Fridovich, I. Assaying for superoxide dismutase activity: Some large consequences of minor changes in conditions. Anal. Biochem. 1987, 161, 559–566. [Google Scholar] [CrossRef] [PubMed]
- Nakano, Y.; Asada, K. Hydrogen peroxide is scavenged by ascorbate-specific peroxidase in spinach chloroplasts. Plant Cell Physiol. 1981, 22, 867–880. [Google Scholar]

| Gene Function | Gene Number | Genes Name |
|---|---|---|
| nitrogen compound metabolic process | 515 | ntcA and nifS |
| phosphorus metabolic process | 160 | Pqq, pstA, pstB, and pstS |
| IAA production | 60 | AdhR, aroA, and trpA |
| Iron carrier synthesis | 19 | Fer, pksS, and rub3 |
| antioxidant activity | 16 | CAT, SOD, and peroxidase |
Disclaimer/Publisher’s Note: The statements, opinions and data contained in all publications are solely those of the individual author(s) and contributor(s) and not of MDPI and/or the editor(s). MDPI and/or the editor(s) disclaim responsibility for any injury to people or property resulting from any ideas, methods, instructions or products referred to in the content. |
© 2024 by the authors. Licensee MDPI, Basel, Switzerland. This article is an open access article distributed under the terms and conditions of the Creative Commons Attribution (CC BY) license (https://creativecommons.org/licenses/by/4.0/).
Share and Cite
Li, G.; Shi, M.; Wan, W.; Wang, Z.; Ji, S.; Yang, F.; Jin, S.; Zhang, J. Maize Endophytic Plant Growth-Promoting Bacteria Peribacillus simplex Can Alleviate Plant Saline and Alkaline Stress. Int. J. Mol. Sci. 2024, 25, 10870. https://doi.org/10.3390/ijms252010870
Li G, Shi M, Wan W, Wang Z, Ji S, Yang F, Jin S, Zhang J. Maize Endophytic Plant Growth-Promoting Bacteria Peribacillus simplex Can Alleviate Plant Saline and Alkaline Stress. International Journal of Molecular Sciences. 2024; 25(20):10870. https://doi.org/10.3390/ijms252010870
Chicago/Turabian StyleLi, Guoliang, Miaoxin Shi, Wenhao Wan, Zongying Wang, Shangwei Ji, Fengshan Yang, Shumei Jin, and Jianguo Zhang. 2024. "Maize Endophytic Plant Growth-Promoting Bacteria Peribacillus simplex Can Alleviate Plant Saline and Alkaline Stress" International Journal of Molecular Sciences 25, no. 20: 10870. https://doi.org/10.3390/ijms252010870
APA StyleLi, G., Shi, M., Wan, W., Wang, Z., Ji, S., Yang, F., Jin, S., & Zhang, J. (2024). Maize Endophytic Plant Growth-Promoting Bacteria Peribacillus simplex Can Alleviate Plant Saline and Alkaline Stress. International Journal of Molecular Sciences, 25(20), 10870. https://doi.org/10.3390/ijms252010870






